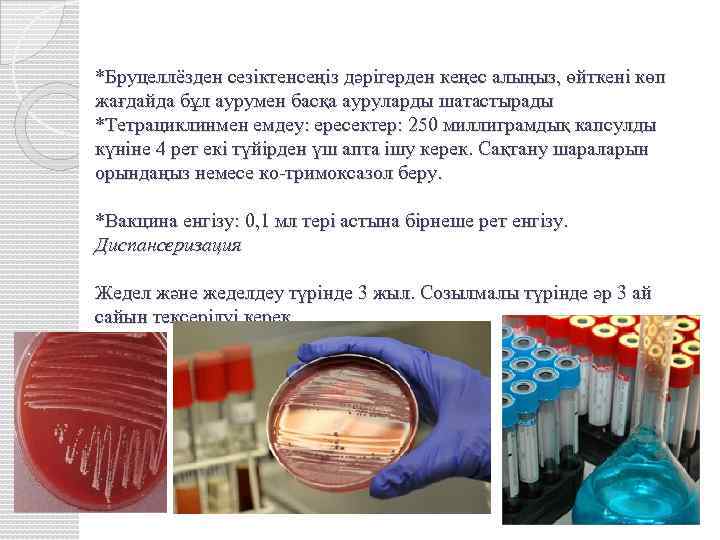

Маябасова Ж инфекц пед.pptx
- Количество слайдов: 27

ҚР ДЕНСАУЛЫҚ САҚТАУ МИНИСТРЛІГІС. Д. АСФЕНДИЯРОВ АТЫНДАҒЫҚАЗАҚ ҰЛТТЫҚ МЕДИЦИНА УНИВЕРСИТЕТІ Кафедра: Тақырыбы : МИНИСТЕРСТВО ЗДРАВООХРАНЕНИЯ РК КАЗАХСКИЙ НАЦИОНАЛЬНЫЙ МЕДИЦИНСКИЙ УНИВЕРСИТЕТ ИМЕНИ С. Д. АСФЕНДИЯРОВА Балалар жұқпалы аурулары Балалардағы бруцеллез (Сарып) Орындаған: Маябасова Жанар 20 -2 к Қабылдаған: Досбаева Ж. Т

Жоспар *Кіріспе: *Этологиясы: *Эпидемиолгиясы: *Патогенезі: *Клиникасы: -Әртүрлі жастағы балалардағы ерекшеліктер *Диагностикасы: *Дифференциалды диагностикасы: *Емі: *Алдын –алу шаралары:

Бруцеллез (Brucellosis) - адам мен малдарда кездесетін, жедел немесе созылмалы түрде өтетін жұқпалы ауру. Ауруды Brucella туыстығына жататын микробтар тудырады. Ауру толқын тәрізді, рецидивті түрде өтеді, жалпы улану симптомы, тірек-қимыл аппаратын зақымдауымен сипатталады.

Алғаш рет бруцеллездің қоздырғышын 1889 жылы, D. Brusel деген ғалым ашқан. Этиологиясы бойынша 6 түрі бар: Br Melitensis (Қара ұсақ мал) Br Abortus bovis Br Abortus suis Br Ovis (қойларда) Br Canis (иттерде) Br Neotomae (егеу қүйрық)

Бруцеллез қоздырғыштары бір-бірінен морфологиясы бойынша айырк қиын. Шар тәрізді 0, 5 -0, 6 мкм және таяқша тәрізді 0, 6 -2, 5 мкм болып келеді. Қозғалмайтын, спора түзбейтін, грам теріс эндотоксин бөлетін қоздырғыш. Қоздырғыш S-формадан R не L формаға өте алады. Бірнеше секунд қайнатқанда 60 С температурада 30 минуттан соң өледі. Күннің жарығы мен УФО 5 -7 минут аралығынды өлтіреді.

Эпидемиологиясы Барлық жерде кең таралған. Инфекция көзі: ауырған ұсақ мүйізді, ірі қара мал, шошқалар, маралдар және адамдар. Таралу механизмі: фекальды-оральды. Берілу жолдары: *қатынас арқылы (зақымдалған тері) *алиментарлық *ауа-шаң (аэрогенді) *көбінесе малшылар, шопандар, ауыл тұрғындары ауырады. *инфекцияның мүмкін болатын көздері

Патогенезі Бруцеллалар ағзаға тері немесе шырышты қабаттар арқылы енеді, сосын макрофактормен ұсталып, сол жерде көбейеді де, лимфа ағынымен регионарлық лимфа түйіндеріне енеді. Содан соң қан тамырлар арқылы бүкіл ағзаға жайылады. *Патогенезінде инфекцияның дамуы бес фазадан өтеді: -лимфогенді фаза -гематогенді фаза -көп ошақты себу жайылу фазасы -экзоошақты себу фазасы -метомффоз фазасы Әр фазаның көрінуі және олардың дамуы организмнің индивидуальды ерекшелігіне байланысты, кіру жеріне, түріне қоздырғыш дозасына және зақымдану шартына байланысты.

Патоморфологиясы Бруцелледегі негізгі зақымдану тамыр жүйесі жағынан болғандықтан (энда, - пери, - панваскулиттер, тромбоваскулиттер) поли ошақтық ағзалардың патологиясы байқалады.

Клиникасы Ол ыстық көтеріліп, қалтырап дірілдеуден басталуы мүмкін, бірақ әдетте бірте-бірте, тез шаршау, әлсіздіқ асқа тәбеттің болмауы, бастың асқазанның буындардың ауыруы формасында өрбиді. Ыстықтың көтерілуі жеңіл және ауыр формада болуы мүмкін. Түстен кейін қалтырап-дірілдеу және ертеңгісін малшынып терлеп қалу бұл ауруға тән белгі. Созылмалы бруцеллёзде ыстық бірнеше күн басылады да сосын қайта көтеріледі. Тиісті ем қолданбаса, бірнеше жылға созылуы мүмкін. Мойында, қолтықтың астында, шапта ісінген лимфа түйіндері пайда болуы мүмкін.

Клиникалық симптомдары орташа алғанда 2 -3 апта өтуімен сипатталады. Жіктелуі: Ағымы бойынша: *жеңіл *орташа *ауыр Ұзақтығы бойынша: *жедел (3 айға дейін) *жеделдеу (6 айға дейін) *созылмалы (6 айдан кейін) -асқыну -рецидивті -латентті *ирезидуальды

Жедел бруцеллездегі симптомдар: Әр түрлі сипаттағы қызба (толқын тәріздес, ремиттирлеуші, субфебрильді) 1 -2 аптадан 2 -3 айға дейін. Қалтырау және тершеңдік Жалпы интоксикациялық синдром (бас ауру, әлсіздік) Микрополиаденит Гепатомиенальдық синдром Қысқа мерзімдік әлсіз немесе айқын түрдегі артралгия, миалгиялар.

Жеделдеу бруцеллезге тән симптомдар: айқын интоксикация ағзалар мен жүйелер зақымдану симптомдары: полиартрит, бруссит, спондилоартриттер, спондиметтер менингит, менингоэнцефалит, миелит, энцефалит эндокардит, миокардит, перикардит нефриттер, нефроздар түсіктер, бедеулік, жатыр түтікшелерінің қабынуы, менистризация циклінің бұзылуы орхит

Созылмалы бруцеллезге тән симптомдар: Висцеральды түрі: жүрек-қантамыр жүйесі тыныс алу жүйесі гепателиенальды синдромдармен жүреді Сүйек буын түрі: буындар сүйектер жұмсақ тіндер аралас түрде зақымдану Нервтік түрі: орталық жүйке жүйесі перифериялық жүйке жүйесінің зақымдалуы психобруцеллез Урогенитальді түрі Клиникалық араласқан түрі

Балалардағы бруцеллездің клиникалық ерекшеліктері Негізгі жұғу жолы: алиментарлы (қайнатылмаған сүт арқылы). Ауру біртіндеп басталады, көбінесе қызба болмайды, субфибрильді болады. Терісі бозғылт, эрт. бөртпелер байқалады, 915%. Лимфа түйіндері сирек үлкейеді. Тірек-қимыл жүйесі жағынан әлсіз өзгерістер байқалады Перифериялық-жүйке жүйесі, зәр шығару жүйесі сирек зақымданады. Негізгі аяқталуы- сауығу.

Диагностикасы -бактериологиялық: гемакультура жұлын сұйықтығы, синовиальды сұйықтықты қолдану -биологиялық (теңіз шошқаларын зақымдау) -иммунды ферментті анализді антиген, антидене табу үшін ИФА -агрегатгемаглютинация әдісі (АГАР) -серологиялық әдіс: комплемент байланыстыру реакциясы (КБР) -аллергиялық әдіс (ГЗТ)-Бюрне сынамасы

Диагностикалық алгоритмі: - Науқастың шағымдары бойынша анамнез жинау(дене қызуы көтерілуі, жалпы улану белгілері). Ауру малмен қарым-қатынаста болуы. Өзіндік ем немесе препараттар қолданлдыма. - Лабораториялық зерттеулер жүргізу





Дифференциалдық диагностикасы: -ЖРА -Іш сүзегімен -Қу-қызбамен -Безгек -Эпидемиялық бөртпе сүзегімен -Бриль ауруымен жүргізіледі -Ревматизм -Сепсис -Жұқпалы мононуклеоз -Лимфогранулематоз -Туберкулез -Басқазооноздар

Емдеу жолдары *Этиотропты: рифампицин, доксициклин, тетрациклин қабылдауға қарсы: вольтарен, напроксен *дезинтокциялық: тек ауыр түрінде -антигистаминді *иммунды жүйені қалыптастыру: левамизол, тимамен *витаминтерапия *физио және симптомдық *санаторлы-курортық *Бруцеллёзден сезіктенсеңіз дәрігерден кеңес алыңыз, өйткені көп жағдайда бұл аурумен басқа ауруларды шатастырады *Тетрациклинмен емдеу: ересектер: 250 миллиграмдық капсулды күніне 4 рет екі түйірден үш апта ішу керек. Сақтану шараларын орындаңыз немесе ко -тримоксазол беру. *Вакцина енгізу: 0, 1 мл тері астына бірнеше рет енгізу. Диспансеризация Жедел және жеделдеу түрінде 3 жыл. Созылмалы түрінде әр 3 ай сайын тексерілуі керек.
*Бруцеллёзден сезіктенсеңіз дәрігерден кеңес алыңыз, өйткені көп жағдайда бұл аурумен басқа ауруларды шатастырады *Тетрациклинмен емдеу: ересектер: 250 миллиграмдық капсулды күніне 4 рет екі түйірден үш апта ішу керек. Сақтану шараларын орындаңыз немесе ко-тримоксазол беру. *Вакцина енгізу: 0, 1 мл тері астына бірнеше рет енгізу. Диспансеризация Жедел және жеделдеу түрінде 3 жыл. Созылмалы түрінде әр 3 ай сайын тексерілуі керек.

Алдын алу Қайнатылған немесе пастерленген сүтті ішу. Бруцеллёз тараған жерлерде қайнатыпмаған сүттен дайындалған ірімшікті жеуден тартынған жөн. Ауру малдарды бағып-күткен кезде аса сақ бопыңыз, әсіресе сіздің денеңізде жырылған немесе тілінген жер болса. Ветеринария қызметкерлерімен кеңесіңіз, қолыңыздағы малдың денсаулығын қадағалап отырыңыз.

Қорытынды: мүйізді ірі қара арасында бруцеллез инфекциясыныңкеңінен таралуына байланысты аудан аумағындаға мал басын толығымен ссрологиялық зерттеуден өткізіп ауру анықталған малдар дереу жойылып, тұрған орындары зарарсыздандырылуы керек. Және ауданаумағындағы барлық аталық малдар (бұқалар) қатаң есепте болуы тиіс және ай сайын брузеллезге тексріліп тұруы қажет. Сонымен қатар аудандық аумақтаң басқармада жұмыс жасайтын мал дәрігер мамандарын осы ауруға байланысты шаралар жауапкершілікпен жүргізілуін қолға алу керек. Медицина қызметі бір ай ішінде аудан аймағында анықталған ауру мал иелерінің от басы бруцеллезге зерттеуге баса назар аударуы қажет.

Қолданылған әдебиеттер: -↑ “Қазақ Энциклопедиясы”, ЫЫ-том Вернер, Дэвид. Халыққа медициналық жәрдем көрсету жөніндегі (Анықтамалық). Қазақ тіліне аударғандар: Айымбетов М, Бермаханов А. —Алматы: "Демалыс", "Қазақстан", 1994— 506 бет. -Тимченко”Детские инфекционные болезни” 2001 г

1. X. Абиджанов М. С. Применение противобруцеллезной вакцины из неагглютиногенного штамма "Невский-12"// Бруцеллез и туберкулез сельскохозяйственных животных: Материалы Международной конференции МЭБ (28 шош-2 ишя 1965 г. ). М. : Колос, 1967. -С. 175 -179. 2. Абсатиров Г. Г. Некоторые особенности эпизоотического процесса при бруцеллезе крупного рогатого скота в хозяйствах мясного направления// Тр. науч. конф. ученых, посвящ. 110 годовщине со дня рождения В. И. Ленина/ Каз. НИВИ. Алма-Ата, 1989. -С. 43 -46. 3. Авилов В. М. Прогнозирование эпизоотического процесса при бруцеллезе крупного рогатого скота в Российской Федерации: Автореф. дже. . канд. вет. наук. Санкт-Петербург, 1992. -23 с. 4. Акчурин Б. С. Изучение эпизоотического значения крупного рогатого скота, Длительно сохраняющего поствакцинальные реакции (РА и ТОК)// Тр. ВИЭВ. М. , 1967. - Т. ХХХШ. -С. 187 -195'. ' 5. Алиев Э. А. Применение вакцины (против бруцеллеза) из штамма 82 на крупном рогатом скоте ж буйволах// Науч. тр. Казан. вет. ин-та. 1980 (1981). - ТЛ 35. - С. 70 -74. 6. Амиреей С. А. , Саттаров А. И, , Иванов I. IL Эпидемиология и эпизоотология бруцеллеза. Алма-Ата: Наука» 1986. -175 с. 7. Аскерова С. А. Дифференциальная диагностика больных и вакцинированных против бруцеллеза животных// Бюл. ШЭВ, - 1985. Т. 57. - С. 12 -15. 8. Бабкин А. Ф. , Литус Э. В. , Яновская Р. Э. Эпидемиологический аспект бруцеллеза овец: Тез. докл. Всесоюз. конф. "Акт. вопросы профилактики бруцеллеза и организации мед. помощи больным" (Новосибирск, 24 -25 окт. , 1989). -М. , 1989. -С. 121 -122. 9. Бажин М. А. Особенности первичного и вторичного иммунных ответов в связи с возрастом телят и дозой бруцелл: Автореф. дис. . канд. вет. наук. Троицк, 1974. - 21 с. 10. Бажин М. А. и др. Иммунологическая толерантность у телят к бруцеллем: Сб. науч. тр. / Сиб. НИВИ. 1976. - Вып. 27. -С. 7 -12. 11. Базалей Ф. К. , Евтенко 1. Т. , Евстаджади К. М. Результаты применения противобруцеллезной вакцины из слабоагглютиногенного штамма 82 на крупном рогатом скоте// Науч. тр. Казан, вет. ин-та. 1980 (1981). - Т. 135. - С. 84 -90. 12. Бакулов И. А. , Котляров В. М. , Белоусов В. Е. Эпизоотологический мониторинг за листериозом животных. Ветеринария, 1989. - Ш 5. - С. 43 -46. 13. Бакулов И. А. Законы и категории эпизоотологии. -Вестн. с. -х. науки. 1994. - Jfc I. - С. 44 -47. 14. Бароян О. В. , Портер Д. Р. Международные и национальные аспекты современной эпидемиологии и микробиологии. М. , 1975. - 300 с. 15. Батуров О. В. , Богомолова М. Г. , Константинов В. М. Компьютерная база данных для оценки регионального риска проявления особо опасных инфекций: Тез. докл. Ш Всесоюз. конф. по эпизоотологии. Новосибирск, 1991. - С. 7 -8. 16. Белобаб В. И. Влияние антибактериального препарата Каз-НИВИ на наличие противобруцеллезных антител у больных животных, иммунизированных вакциной из штамма 19// Вестн. с. -х. науки Казахстана. 1991. - Я 3. - С. 77 -79. 17. Белозерова Г. Н. Получение и испытание живой вакцины против бруцеллеза из штамма 82 -пч: Автореф. дис. . д-ра вет. наук. Казань, 1993. - 38 с. 18. Белозеров Е. Г. Бруцеллез. -Л. : Медицина, Ленинградское отд-ние, 1985. 183 с. 19. Беляков В. Д. Эпидемический процесс (теория и метод изучения). Л. : Медицина, 1964. - 244 с.
Маябасова Ж инфекц пед.pptx